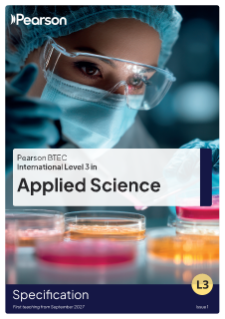
BTEC International Level 3 in Applied Science Specification

BTEC International Level 3 Applied Science (2027)
Specification
Qualification Summary
Title: Pearson BTEC International Level 3 Applied Science
First teaching: September 2027
Availability: International only
Last registration: 31 August 2032
Final certification: 31 August 2035
These qualifications offer progressive routes in applied science, from Certificate to Extended Diploma sizes.
Students develop practical, theoretical and transferable skills through mandatory and optional units in biology, chemistry, physics and contemporary science topics. Designed for flexible study, they support progression to higher education or employment in science-related sectors, with increasing depth and specialisation at each size.
Irine Muhiuddin
Science

Want to teach this qualification?
Talk to us today and we'll make sure you have the latest news and guidance to support to you.
Blended learning digital resources
Digital Teacher Resource Packs include introductory PowerPoint presentations slides and classroom activities, individual or group worksheets and interactive knowledge check quizzes for each of the learning aims within the specification.